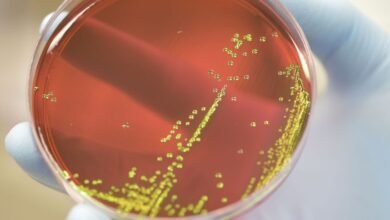

Ciências
-

Vício em games é reconhecido como doença pela OMS; saiba como identificar
Agora é oficial. O chamado distúrbio de games é considerado uma doença pela Organização Mundial da Saúde (OMS). O que sacramentou…
Leia mais » -

Anvisa indefere pedidos de registro de três autotestes de covid-19
A Agência Nacional de Vigilância Sanitária (Anvisa) indeferiu pedidos de registros de três autotestes de covid-19. De acordo com a…
Leia mais » -

Vacinas para crianças de 5 a 11 anos serão distribuídas até o dia 15
Até o dia 15 de fevereiro, todas as doses para a vacinação de crianças entre 5 e 11 anos de…
Leia mais » -

Brasil recebe mais 2,1 milhões de doses de vacinas da Pfizer
Mais de 2,1 milhões de doses da vacina da Pfizer contra a covid-19, voltadas para o público acima de 12…
Leia mais » -

Cientistas descobrem subvariante da Ômicron ainda mais infecciosa
A subvariante BA.2 da cepa do coronavírus Ômicron, que rapidamente assumiu o controle na Dinamarca, é mais transmissível do que…
Leia mais » -

Anvisa aprova uso e comercialização de autoteste para covid-19
A diretoria colegiada da Agência Nacional de Vigilância Sanitária (Anvisa) aprovou hoje (28), por unanimidade, o uso e a comercialização,…
Leia mais » -

Vitamina D e ômega 3 podem prevenir doenças autoimunes, diz estudo
Pesquisadores da Universidade de Harvard, nos Estados Unidos, descobriram que a suplementação de vitamina D e óleo de peixe com…
Leia mais » -

Pfizer antecipa entrega de doses da vacina pediátrica contra covid-19
O Ministério da Saúde informou que a Pfizer antecipará mais um lote de 1,8 milhão de vacinas pediátricas contra a…
Leia mais » -

Cientistas descobrem quatro fatores relacionados à Covid longa
Entre os milhões de indivíduos que curados da Covid-19 há um grupo que rapidamente se recupera e volta a condição…
Leia mais » -
Superbactérias matam mais que HIV ou malária, aponta estudo
Um estudo publicado na revista científica The Lancet indicou que mais de 1,2 milhão de pessoas morreram, em 2019, por…
Leia mais »
